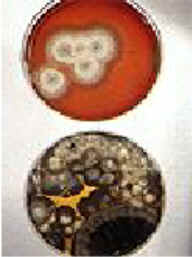

| Healing naturally Dr. David Cohen,
highly effective naturopathic doctor
As with all websites,
your designer is Mister-Shortcut, Godfather of Internet EyeCandy
Learn more in order to live more and give more. It works.
You've reached the world's largest natural health resource. Nothing else comes close,
with many millions & millions of unique pages at
because the more we know, the stronger and longer we tend to live.
The longer and stronger we live, the more we tend to give.
and that's where Mr-Shortcut comes into the picture:
If you're willing to learn, you will learn how to win faster,
how to accelerate your results in pretty much any and every human endeavor you can name.
If you're interested in living stronger and living longer, you've probably come to the right place:
The MisterShortcut Approach is part of the "Masters and Millionaires" network created by your Godfather of Shortcuts,
which, combined, creates the world's largest naturopathic website, and certainly the one our healthiest and wealthiest websites.
Jump in and learn more, the Healthiest Secrets of Life is free for your life,
in hope of you learning more in order to live more so you can give more. Thank you.
Please remember to feed those who are hungrier than you by giving, at no cost to you.

Meritable sponsors donate 1.1 cups of staple food for our free clicks.
By clicking this and the following food buttons, you really do help to save a human life...
at no charge to you.
Share the MisterShortcut Approach With Global Generosity!
Sharing has a funny, pleasing way of returning, repeatedly
You already know that what goes up must come down, that what goes around comes around.
Today presents any number of opportunities for you, some you see, plenty that pass you by.
Today, the MisterShortcut Approach solicits your interest in developing your excellence.
So, pretend that today is that day in which you earn annual money in each work-hour.
Today is your focus, not the next 100 days of repeating and improving what you do today.
You can do it for 22 days, 100 days, 1000 days or more, provided you do it, fully, in THIS today.
What you do plays a distant second fiddle to what you do with what you know, demanding you do more.
When you awaken the MisterShortcut Approach within you, you are going to be positively electrified, as a habit.
When you imitate the best, the masters and millionaires, the champions and billionaires, you tend to imitate their results.
It is your day, your turn, your MisterShortcut Approach, your hunger driving the determination of how successful you will be today.
Share the MisterShortcut Approach and Healthiest Secrets of Life with YOUR world,
for the MisterShortcut Approach and Healthiest Secrets of Life can be used by all.
The more we give away in life, the more that life is sure to repay our kindness.
Empower people to empower themselves, effectively teaching us all to help.
The helpless of the world, humans and creatures, all within air, sea, land,
all cry out to you to reverse the unconscionable greed of the wealthiest.
Share the MisterShortcut Approach and Healthiest Secrets of Life today.
Help to even up the playing field, living a life that lives beyond you.
All the hundreds of thousands of pages in The MisterShortcut Approach and beyond were created and individually refined
by a single pair of hands laboring with love to bring you the greatest and healthiest shortcuts of all time.
ALL possible because of the geniuses and pioneers who share their excellence, generously.
Wait it gets better.
There are also between three hundred and five hundred thousand additional unique pages,
focusing on the greatest shortcuts of masters and millionaires, champions and billionaires,
ALSO created by that same pair of hands, beginning here at The MisterShortcut Approach,
and continuing through all the other "Psychology of _________" empowerment websites.
All of this EyeCandy and terrific PowerGems as well, hundreds of thousands of pieces,
were often created in batches, and then opened individually to uniquify them.
Opening hundreds of copies of a page provides freedom to be expressive.
To each was added snippets of delicious EyeCandy interactive effects.
At last count, you should find thousands of original chapters,
with anywhere from one hundred to more than a thousand
distinctly discrete versions of each PowerGem chapter.
The largest body of work ever created by one human.
Fifty-one thousand highly focused hours for you.
That's how much love you will find here:
hundreds of thousands of pieces...
particularly for you and yours,
Learn, live, & give more..
Mr-Shortcut
|
|
Your own personal sycophant,
the Godfather of EyeCandy, the Godfather of Shortcuts,
offers up the MisterShortcut Approach
The MisterShortcut Approach certainly qualifies for "World's Biggest Natural Healing Website."
Decide for yourself whether it is your healthiest website.
Using the best health tips of people who live stronger for longer is wise.
The Healthiest Secrets of Life is designed for your life,
with the understanding that you will make use of its wisdom,
that you'll enjoy the fruits of its successful experience,
and then have the decency to pass it to those who need it.
There is always someone worse off than us, individually and otherwise.
Without exception, each time you considerately think of them, or act for them,
the universe and all of its laws gives you the positively sumptious guarantee of return.
You already know that anything we do has equal and opposite reaction.
What might distract you into thinking that this fact is immune?
The rules of life that hold true most of all, all PowerGems,
apply to all we survey. Faith and science combined.
Created by your Godfather of EyeCandy,
The MisterShortcut Approach is vast
IE users: Tap any keyboard letter, number or character (even upper-case!) for another Mr-Shortcut website of EyeCandy and self-empowerment
MisterShortcut believes that each of us has greatness inside.
That's why you are presented with more than a hundred of these healthiest websites, including
filled with your best health tips for living stronger for longer... naturally
Always remember that no vitamin or human or surgery can cure or heal us; they can only help us to heal ourselves!
Natural chelation therapy, as recommended by top doctors of natural medicine,
top doctors of naturopathy and natural healing, who repeatedly prove that we are born with the necessary tools for healing.
Natural chelation therapy is healthier! Surely all top doctors can agree on this:
natural chelation therapy is healthier, natural chelation therapy is safer!
|
Ozone and ultraviolet toothbrush sterilizers don't work. You can find fungus actually growing inside the ultraviolet toothbrush sterilizers. The only solution is to use a new toothbrush every time. Our disposable toothbrushes use new bio-degradable material every
time you brush your teeth. Best of all, they outperform every toothbrush on the market. Try brushing your teeth with the biological hazard you are currently using, then try our disposable brush. The difference is
amazing.
Ozone and ultraviolet toothbrush sterilizers don't work. You can find fungus actually growing inside the ultraviolet toothbrush sterilizers. The only solution is to use a new toothbrush every time. Our disposable toothbrushes use new bio-degradable material every
time you brush your teeth. Best of all, they outperform every toothbrush on the market. Try brushing your teeth with the biological hazard you are currently using, then try our disposable brush. The difference is
amazing. 
